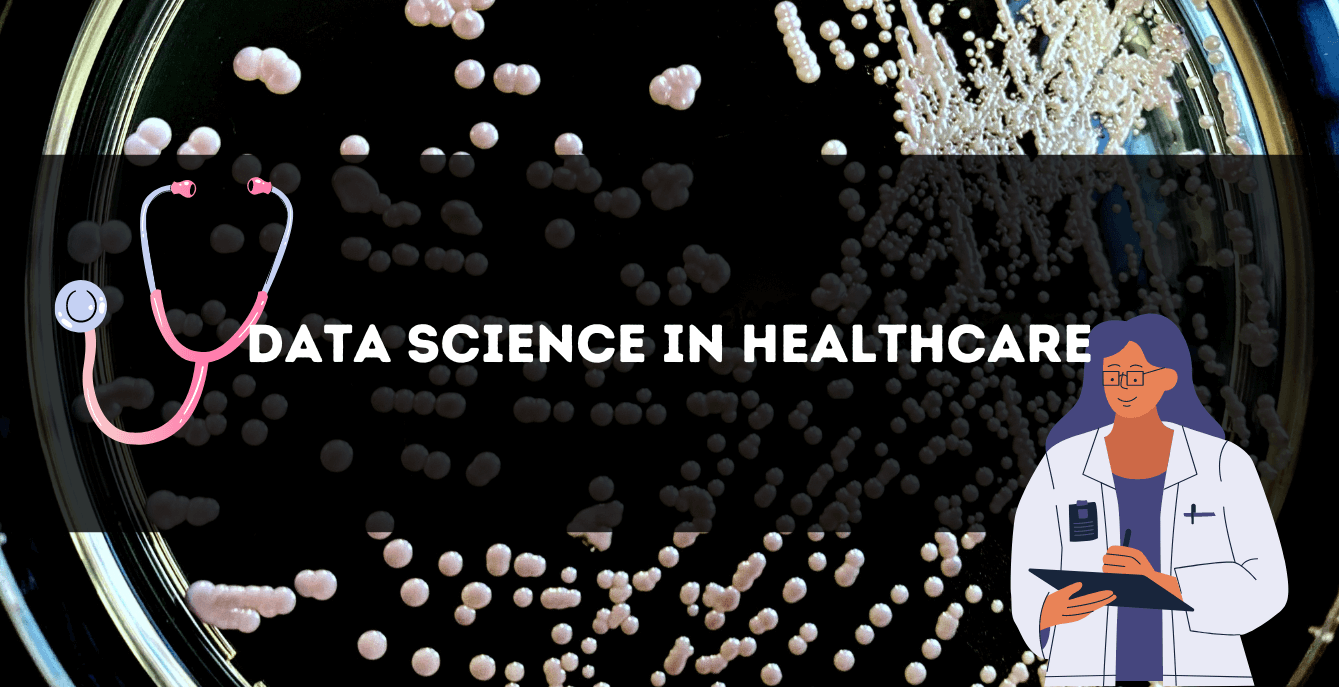
EMPOWERING HEALTHCARE THROUGH DATA SCIENCE

Today's world is very dynamic. And in this world, where information is abundant and technology is ever-evolving, data science has emerged as a transformative force across industries. With its ability to extract valuable insights from vast amounts of data, it has become an indispensable tool for decision-making and innovation. While its impact spans various sectors, few can argue against the vital role data science plays in the healthcare industry.
As we navigate the complexities of an increasingly digital world, the healthcare landscape faces unique challenges that demand efficient solutions. From improving patient outcomes and streamlining operations to driving medical breakthroughs and enhancing public health initiatives, the effective utilization of data science is paramount. In the United Kingdom, a country renowned for its commitment to quality healthcare, the fusion of data science and healthcare has opened new doors for advancement and progress.
Bilginç IT Academy recognizes the significance of data science in healthcare and is dedicated to empowering HR professionals and data scientists working in the healthcare sector across the United Kingdom. With our comprehensive range of data science courses, including both in-person training in England and instructor-led virtual classrooms accessible from anywhere, we aim to equip individuals with the knowledge and skills necessary to harness the power of data and revolutionize the healthcare industry.
In this article, we will explore the myriad ways in which data science is transforming healthcare in the UK. From enhancing clinical decision-making to optimizing resource allocation, we will delve into the pivotal role of data science in this critical sector. Furthermore, we will shed light on how Bilginç IT Academy's data science courses can serve as a catalyst for professionals seeking to elevate their expertise and contribute to the future of healthcare.
Why Do We Use Data Science in Healthcare?
Data science has emerged as an indispensable tool within the healthcare industry, revolutionizing the way patient care is delivered and transforming healthcare systems as a whole. Here are several compelling reasons why data science has become an integral part of healthcare:
Unleashing the Power of Data:
In healthcare, vast amounts of data are generated daily, ranging from electronic health records and medical imaging to genomics and wearable devices. Data science enables the efficient collection, storage, and analysis of this wealth of information, unlocking invaluable insights that can drive evidence-based decision-making, personalized treatments, and predictive analytics.
Enhanced Clinical Decision-Making:
Data science empowers healthcare professionals with tools and techniques to make more informed and precise clinical decisions. By leveraging advanced algorithms and machine learning models, data science can analyze patient data, identify patterns, and predict outcomes. This enables clinicians to diagnose diseases earlier, tailor treatment plans, and improve patient outcomes.
Solve Problems and Make Decisions Training in United Kingdom
Improving Operational Efficiency:
Efficient resource allocation and streamlined operations are crucial for delivering quality healthcare services. Data science plays a vital role in optimizing healthcare operations, reducing costs, and enhancing efficiency. Through data-driven insights, healthcare organizations can identify bottlenecks, optimize workflows, forecast patient demands, and allocate resources effectively, ensuring optimal utilization of personnel, equipment, and facilities.
Advancing Medical Research:
Data science has the potential to revolutionize medical research and accelerate scientific breakthroughs. By analyzing vast amounts of medical data, researchers can uncover patterns, identify risk factors, and develop new treatment methods. Data science techniques such as predictive modeling and natural language processing can aid in drug discovery, clinical trial optimization, and precision medicine, ultimately leading to innovative therapies and improved patient outcomes.
Public Health Initiatives:
Data science plays a critical role in addressing public health challenges and enabling proactive interventions. By analyzing population-level data, data scientists can identify disease trends, detect outbreaks, and monitor the effectiveness of public health initiatives. This information guides policymakers in making data-informed decisions, implementing preventive measures, and allocating resources to prevent the spread of diseases and promote public well-being.
Virtual Assistance:
In today's healthcare landscape, data scientists have harnessed the power of technology to create chatbots and AI platforms that offer virtual assistance. These innovative tools enable individuals to input their health information and receive accurate diagnoses, empowering them with a better understanding of their well-being. Additionally, these platforms provide assistance with health insurance policies and offer personalized lifestyle guides. By leveraging data science techniques, virtual assistants enhance accessibility to healthcare information, deliver tailored guidance, and facilitate efficient healthcare interactions, ultimately enhancing the overall healthcare experience for individuals.
Incorporating data science into healthcare practices empowers healthcare professionals, improves patient care, and drives transformative changes in the industry. By embracing data science methodologies and leveraging the expertise gained from Bilginç IT Academy's data science courses, HR professionals and data scientists in the healthcare sector can harness the full potential of data to revolutionize healthcare delivery, improve outcomes, and pave the way for a healthier future.

Data Scientist's Role in Healthcare
Data scientists have emerged as crucial participants in fostering innovation, promoting patient care, and enhancing healthcare outcomes in the constantly changing healthcare sector. With their unique blend of technical expertise and domain knowledge, data scientists play a pivotal role in transforming healthcare organizations into data-driven entities. Here are some key aspects of a data scientist's role in healthcare:
Gathering and Combining Data:
Finding and gathering pertinent data from numerous sources inside healthcare institutions is the responsibility of data scientists. They deal with data from wearable devices, genetics, electronic health records, medical imaging, and other datasets connected to healthcare. Data scientists are capable of combining and integrating many data sources, resulting in a comprehensive and coherent analysis picture.
Data Preprocessing and Cleaning:
Healthcare data is frequently cluttered and complex, with errors, missing numbers, and discrepancies. To assure data quality and reliability, data scientists make use of cutting-edge data cleaning and preprocessing techniques. To handle missing data and eliminate outliers, they use statistical approaches and data imputation techniques, ensuring the correctness and integrity of the data used for analysis.
Predictive Modeling and Machine Learning:
Data scientists utilize predictive modeling and machine learning algorithms to uncover patterns, derive insights, and make predictions in healthcare. They develop models that can predict patient outcomes, identify disease risk factors, and optimize treatment plans. These models assist healthcare professionals in making data-driven decisions, enhancing clinical decision-making, and delivering personalized care.
Feature Engineering and Selection:
To build effective predictive models, data scientists engage in feature engineering and selection. They identify the most relevant features or variables within the data that contribute to the predictive power of the models. By selecting and engineering the right set of features, data scientists improve the accuracy and interpretability of the models, enabling healthcare professionals to make informed decisions based on the identified factors.
Data Visualization and Interpretation:
Data scientists have the ability to transform complex healthcare data into meaningful visualizations and interactive dashboards. They leverage data visualization tools to present insights in a visually appealing and easily understandable manner. Through effective data visualization, data scientists help healthcare professionals and stakeholders gain actionable insights, facilitating communication and informed decision-making.
Ethical Considerations and Privacy:
In the United Kingdom, data scientists in healthcare must adhere to rigorous ethical standards and ensure the protection of patient privacy and data security. They operate within the framework of established regulations, including the Data Protection Act 2018 and the General Data Protection Regulation (GDPR). These regulations outline guidelines for the lawful and responsible handling of personal and sensitive healthcare data.
Moreover, data scientists in the UK collaborate closely with healthcare organizations' Information Governance teams to ensure compliance with legal and ethical requirements. They actively participate in data governance frameworks, conducting privacy impact assessments and risk assessments to identify and mitigate potential data breaches or security vulnerabilities.
Sharing of Information and Collaboration:
Within healthcare organizations, data scientists work with diverse teams that include healthcare practitioners, researchers, and IT specialists. They serve as a conduit for complex ideas and discoveries between technical and non-technical parties. In order to promote a data-driven culture within healthcare organizations, data scientists also participate to knowledge sharing programs by leading seminars, training sessions, and sharing best practices.
By leveraging their expertise and skills, data scientists empower healthcare organizations to make informed decisions, improve patient outcomes, and drive innovation. Their contributions in data collection, cleaning, analysis, and interpretation help unlock the immense potential of healthcare data, paving the way for personalized medicine, proactive interventions, and a more efficient healthcare system overall.

How to Become Healthcare Data Scientist in 2023
The healthcare sector is one of the UK's emerging sectors in need of development. The National Health Service, or NHS, is the name of the government-run healthcare program in the United Kingdom. The NHS is in charge of managing every area of the British healthcare system. One of the biggest public health systems in the world today is the NHS.
The demand for data scientists in the UK's healthcare industry stems from the recognition that data-driven insights and innovation have the potential to revolutionize patient care, optimize healthcare operations, and address complex healthcare challenges. Data scientists bring a unique skill set that combines domain knowledge, statistical expertise, and computational skills, making them invaluable assets in leveraging the power of data to transform the healthcare landscape.
Key Skills Required to Become a Data Scientist:
- Proficiency in programming languages like Python and R
- Statistical analysis
- Machine learning techniques
- Data visualization
- Problem-solving
- Domain knowledge
- Strong communication
- Storytelling abilities
If you are already a data scientist working in the UK and want to transition to the healthcare sector, your job is easier! You can read studies on how data is used in the healthcare sector, examine case studies and attend trainings tailored to the needs of this sector.
If you are just starting data science, we can recommend the following trainings for you. As Bilginç IT Academy, we offer these trainings both in our classrooms in different cities of the UK and in our virtual classrooms. You can contact us if you need help to find the right option and the right training for you.
Keep in mind: The programmign languages commonly used in data science are Python and R. You'll want to learn these programming languages to thrive in your data science career!
Data Science Boot Camp Training in United Kingdom
Practical Data Science with Python Training
Fundamentals of Data Science Training in United Kingdom
Hands-On Data Science with R Course
Building the In-Demand Skills for Analytics and Data Science Training
We offer many free e-books that you can download! Here are some suggestions for you:
Practical Statistics for Data Scientists
We are the leader in corporate training! With nearly 30 years of experience, we provide technology training to organisations and train their teams. Our trainings in the field of data science are truly pioneering and specialised. If you work in healthcare and need to upskill your data science team, you've come to the right place! Contact us today and find out how the UK's leading organisations are utilising data.